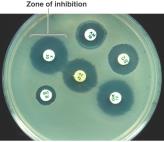
Kirby-Bauer disk diffusion test

Back
BackControlling Microbial Growth in the Body: Antimicrobial Drugs and Resistance
Study Guide - Smart Notes

Controlling Microbial Growth in the Body
Introduction to Antimicrobial Control
Controlling microbial growth within the human body is essential for treating infectious diseases. Unlike physical methods such as incineration, which cannot be used in living hosts, antimicrobial drugs are designed to selectively target pathogens without harming the host. The principle of selective toxicity is central to effective antimicrobial therapy.
Selective toxicity: The ability of a drug to target microbial cells without damaging host cells.
Chemotherapeutic agents: Chemicals used to treat diseases, including antimicrobials for infections.
Key Point: Drugs must be toxic to microbes but safe for the host.
Sources and History of Antimicrobial Agents
Most antimicrobials are secondary metabolites produced by fungi and bacteria. These natural compounds likely evolved as a means for microbes to compete with each other in their environments.
Salvarsan (arsphenamine): First modern chemotherapeutic agent (1910), used to treat syphilis.
Penicillin: Discovered by Alexander Fleming in 1929, produced by Penicillium mold, became widely available in the 1940s.
Sulfanilamide: First widely used antimicrobial agent (1932), inhibits nucleotide synthesis.


Mechanisms of Antimicrobial Action
Overview of Drug Targets
Antimicrobial drugs exploit differences between microbial and host cells. The main mechanisms include inhibition of cell wall synthesis, protein synthesis, nucleic acid synthesis, metabolic pathways, disruption of membranes, and inhibition of pathogen attachment.
Antibacterial drugs: Most numerous and diverse due to unique bacterial structures (e.g., peptidoglycan cell wall).
Antifungal, antiprotozoan, antihelminthic, and antiviral drugs: Fewer in number due to similarities between eukaryotic pathogens and host cells, or the unique biology of viruses.

Inhibition of Cell Wall Synthesis
Many antibiotics, such as beta-lactams, prevent the cross-linking of peptidoglycan in bacterial cell walls, leading to cell lysis. These drugs are effective only against growing cells and do not affect animal or plant cells, which lack peptidoglycan.
Beta-lactams: Bind to enzymes that cross-link NAM subunits in peptidoglycan.
Semisynthetic derivatives: Modified to improve stability, absorption, and spectrum of activity.


Inhibition of Protein Synthesis
Prokaryotic ribosomes (70S) differ from eukaryotic ribosomes (80S), allowing selective targeting. However, mitochondrial ribosomes in eukaryotes are similar to prokaryotic ribosomes, which can lead to side effects.
Aminoglycosides (e.g., streptomycin): Cause misreading of mRNA.
Tetracyclines: Block tRNA docking site.
Chloramphenicol: Inhibits peptide bond formation.
Macrolides (e.g., erythromycin): Block ribosome movement.
Antisense RNA: Prevents ribosome assembly.






Disruption of Cytoplasmic Membranes
Some drugs, such as amphotericin B, bind to ergosterol in fungal membranes, forming pores and causing cell death. Bacterial membranes are not affected due to the absence of sterols.

Inhibition of Metabolic Pathways
Antimetabolic agents target enzymes unique to the pathogen. Sulfa drugs, for example, inhibit folic acid synthesis, which is essential for nucleotide biosynthesis in bacteria but not in humans.

Inhibition of Nucleic Acid Synthesis
Nucleic acid analogs mimic normal nucleotides but terminate DNA or RNA synthesis, particularly in viruses with error-prone polymerases. Examples include acyclovir (herpes), remdesivir (COVID-19), and retrovir (HIV).
Inhibition of Pathogen Attachment
Some antivirals, such as Relenza and Tamiflu, inhibit neuraminidase in influenza viruses, preventing the release and spread of new virions.

Spectrum of Antimicrobial Activity
Broad vs. Narrow Spectrum
Broad-spectrum drugs target a wide range of microbes but may disrupt normal flora, leading to secondary infections. Narrow-spectrum drugs are more selective.

Efficacy and Administration of Antimicrobial Drugs
Testing Antimicrobial Effectiveness
Disk-diffusion (Kirby-Bauer) test: Measures zone of inhibition around antibiotic disks.
Minimum inhibitory concentration (MIC): Lowest concentration preventing visible growth.
Minimum bactericidal concentration (MBC): Lowest concentration that kills bacteria.

Routes of Administration
Topical: Direct application to skin for external infections.
Oral: Simple but relies on patient compliance.
Intramuscular (IM): Injection into muscle tissue.
Intravenous (IV): Directly into bloodstream; achieves highest drug levels quickly.

Safety, Side Effects, and Resistance
Adverse Effects of Antimicrobials
Toxicity: Some drugs damage kidneys, liver, or nerves; tetracyclines can affect teeth and bones.
Allergies: Rare but potentially life-threatening.
Disruption of normal flora: Can lead to overgrowth of opportunistic pathogens (e.g., Candida albicans or Clostridium difficile).

Development of Resistant Organisms
Bacteria can acquire resistance through mutations or horizontal gene transfer (transformation, transduction, conjugation). Incomplete treatment or overuse of antibiotics accelerates resistance.

Mechanisms of Bacterial Resistance
Enzymatic inactivation of drugs (e.g., beta-lactamase destroys penicillin).
Prevention of drug entry (altered membrane proteins).
Alteration of drug targets (e.g., modified ribosomes or enzymes).
Metabolic pathway changes.
Efflux pumps expel drugs from the cell.


Strategies to Retard Resistance
Maintain high drug concentrations to kill all sensitive cells.
Use drug combinations (synergism).
Limit use to necessary cases.
Develop new drugs or modify existing ones (second- and third-generation drugs).

Table: Sources of Common Antibiotics and Semisynthetics
Microorganism | Antimicrobial |
|---|---|
Fungi | |
Penicillium chrysogenum | Penicillin |
Penicillium griseofulvum | Griseofulvin |
Cephalosporium spp. | Cephalosporin |
Bacteria | |
Bacillus licheniformis | Bacitracin |
Bacillus polymyxa | Polymyxin |
Micromonospora purpurea | Gentamicin |
Pseudomonas fluorescens | Mupirocin |
Streptomyces griseus | Streptomycin |
Streptomyces fradiae | Neomycin |
Streptomyces aureofaciens | Tetracycline |
Streptomyces venezuelae | Chloramphenicol |
Streptomyces erythreus | Erythromycin |
Streptomyces orientalis | Vancomycin |
Streptomyces nodosus | Amphotericin B |
Streptomyces avermitilis | Ivermectin |
